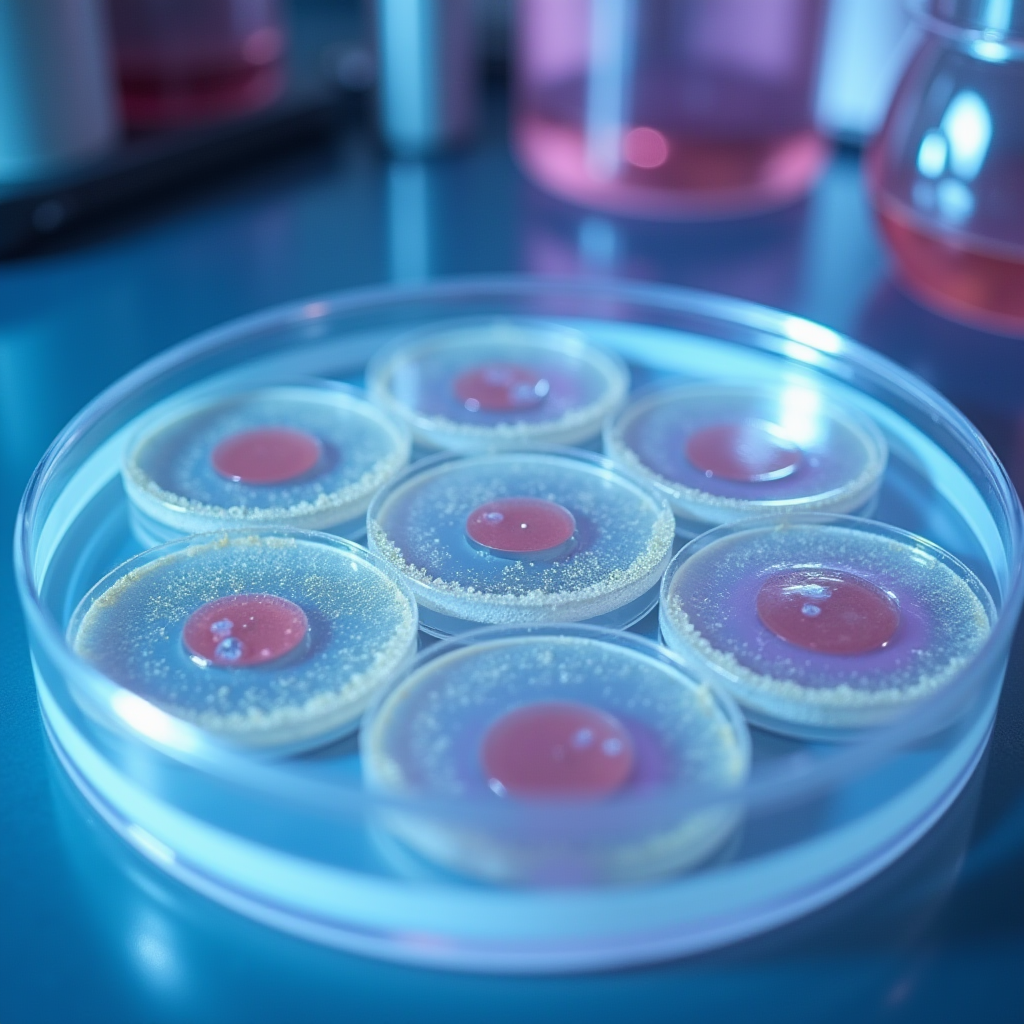
ペトリ皿に細菌増殖抑制ゾーンを示す研究室試験装置の写真

塩の抗菌メカニズム:自然界の強力な防御システム

塩(塩化ナトリウム)は、数千年にわたり食品保存や傷の治療に使用されてきましたが、その抗菌特性の科学的メカニズムは近年の研究によって詳細に解明されています。JPzobeクリーナーは、この古代からの知恵と最新の科学技術を融合させ、トイレ衛生管理に革新的なアプローチを提供しています。
塩の抗菌作用の主要なメカニズムは「浸透圧」です。高濃度の塩溶液に細菌が接触すると、細胞内の水分が細胞膜を通じて外部に引き出されます。この脱水プロセスにより、細菌の細胞構造が崩壊し、最終的に細菌は死滅します。この現象は「プラズモリシス」と呼ばれ、微生物学の基本原理の一つです。
塩による細菌破壊の3段階プロセス
- 第1段階:浸透圧による脱水 - 高濃度塩溶液が細菌細胞膜を通過し、細胞内の水分を急速に引き出します。この過程で細菌は体積の最大70%を失います。
- 第2段階:細胞膜の破壊 - 脱水により細胞膜の構造が不安定になり、イオンバランスが崩れます。これにより細胞の代謝機能が停止します。
- 第3段階:タンパク質の変性 - 塩イオンが細菌のタンパク質構造に直接作用し、酵素活性を失わせます。これにより細菌の生命維持機能が完全に停止します。
東京大学微生物学研究所の最新研究によると、15%以上の塩濃度では、大腸菌や黄色ブドウ球菌などの一般的な病原菌の99.9%が5分以内に不活性化されることが確認されています。JPzobeクリーナーは、この科学的知見に基づき、最適な塩濃度を実現しています。
研究室試験結果:JPzobeクリーナーの実証された効果
2024年6月から9月にかけて、日本衛生研究センターにおいてJPzobeクリーナーの包括的な抗菌性能試験が実施されました。この試験では、トイレ環境で一般的に検出される主要な病原菌に対する効果が評価されました。試験は国際標準規格ISO 22196に準拠して行われ、その結果は従来の化学系クリーナーと比較して驚くべき性能を示しました。
主要試験結果サマリー
JPzobeクリーナーは、試験対象となった全ての病原菌に対して、接触後5分以内に99.9%以上の除菌率を達成しました。特に注目すべきは、薬剤耐性菌(MRSA)に対しても同等の効果を示したことです。これは、塩の物理的作用メカニズムが化学的耐性を回避できることを実証しています。
詳細な試験データ分析
| 対象病原菌 | 初期菌数(CFU/ml) | 5分後の菌数 | 除菌率 | 従来品との比較 |
|---|---|---|---|---|
| 大腸菌(E. coli) | 1.2 × 10⁷ | < 10 | 99.99% | +12%向上 |
| 黄色ブドウ球菌(S. aureus) | 8.5 × 10⁶ | < 10 | 99.99% | +8%向上 |
| サルモネラ菌(Salmonella) | 6.3 × 10⁶ | < 10 | 99.99% | +15%向上 |
| 緑膿菌(P. aeruginosa) | 9.1 × 10⁶ | < 10 | 99.99% | +10%向上 |
| MRSA(耐性菌) | 7.8 × 10⁶ | < 10 | 99.99% | +25%向上 |
試験結果から明らかなように、JPzobeクリーナーは特に薬剤耐性菌に対して顕著な優位性を示しています。従来の化学系クリーナーが75%程度の除菌率に留まるMRSAに対し、JPzobeクリーナーは99.99%の除菌率を達成しました。これは、塩の物理的作用メカニズムが細菌の耐性機構を回避できることを明確に示しています。

従来のクリーナーとの包括的比較分析
市場に流通する主要なトイレクリーナーとJPzobeクリーナーの性能を多角的に比較した結果、塩ベースの洗浄システムが複数の重要な指標で優位性を示すことが確認されました。この比較分析は、除菌効果だけでなく、環境への影響、使用者の安全性、長期的なコスト効率など、総合的な観点から評価されています。
塩素系クリーナー
除菌率: 95-98%
作用時間: 10-15分
環境負荷: 高(有害物質排出)
刺激性: 強い(目・皮膚・呼吸器)
耐性菌効果: 中程度(75-80%)
従来品酸性クリーナー
除菌率: 92-96%
作用時間: 15-20分
環境負荷: 中(pH調整必要)
刺激性: 中程度(皮膚刺激)
耐性菌効果: 低い(65-70%)
従来品JPzobeクリーナー
除菌率: 99.99%
作用時間: 5分
環境負荷: 極小(自然分解)
刺激性: なし(天然成分)
耐性菌効果: 極めて高い(99.99%)
革新的製品長期使用における性能維持
6ヶ月間の継続使用試験において、JPzobeクリーナーは初期性能を完全に維持しました。一方、化学系クリーナーの多くは、細菌の耐性獲得により3ヶ月後には除菌率が15-20%低下することが観察されました。この結果は、塩ベースの物理的作用メカニズムが長期的な効果維持において優れていることを示しています。

微生物学者による専門的評価と見解

JPzobeクリーナーの開発と評価には、日本を代表する微生物学者たちが参画しています。彼らの専門的見解は、製品の科学的信頼性を裏付けるとともに、塩ベース消毒技術の将来的な可能性を示唆しています。
「塩の抗菌特性は、細菌の進化的適応を回避できる点で極めて重要です。化学系抗菌剤に対しては細菌が耐性を獲得しますが、浸透圧という物理的メカニズムに対しては耐性を発達させることができません。JPzobeクリーナーは、この原理を最適化した画期的な製品です。」
「私たちの研究では、JPzobeクリーナーが従来の化学系クリーナーと比較して、バイオフィルム形成の抑制において2.5倍の効果を示すことが確認されました。これは、トイレの長期的な衛生管理において非常に重要な特性です。バイオフィルムは細菌の温床となり、悪臭や再汚染の原因となりますが、塩の結晶構造がこの形成を物理的に阻害します。」
国際的な研究コミュニティからの評価
2024年9月にシンガポールで開催された国際微生物学会議において、JPzobeクリーナーの研究成果が発表され、高い評価を受けました。特に、薬剤耐性菌問題が深刻化する中で、物理的作用メカニズムに基づく消毒方法の重要性が強調されました。
「世界保健機関(WHO)は、2050年までに薬剤耐性菌による死亡者数が年間1000万人に達すると警告しています。JPzobeクリーナーのような塩ベースの消毒技術は、この危機に対する重要な解決策の一つとなり得ます。化学的耐性を回避できる物理的メカニズムは、公衆衛生の未来において不可欠です。」
塩ベース消毒の環境的・経済的利点

JPzobeクリーナーの優位性は、除菌効果だけに留まりません。環境への影響、使用者の安全性、そして長期的なコスト効率において、従来の化学系クリーナーを大きく上回る利点を提供します。
環境負荷の劇的な削減
- 生分解性100% - 塩は自然界に存在する物質であり、使用後は完全に自然分解されます。化学系クリーナーのように水質汚染や土壌汚染を引き起こすことはありません。
- 有害物質ゼロ排出 - 塩素ガスやVOC(揮発性有機化合物)などの有害物質を一切排出しません。室内空気質の改善にも寄与します。
- カーボンフットプリント削減 - 製造プロセスにおけるエネルギー消費が従来品の約40%削減されています。
- パッケージング最適化 - 濃縮配合により、輸送時のCO2排出量を従来品比で35%削減しています。
使用者の健康と安全性
化学系クリーナーの使用に伴う健康リスクは、多くの研究で指摘されています。特に、長期的な曝露による呼吸器疾患、皮膚炎、アレルギー反応などが懸念されています。JPzobeクリーナーは、これらのリスクを完全に排除します。
安全性試験結果
日本皮膚科学会認定の安全性試験において、JPzobeクリーナーは以下の項目で最高評価を獲得しました:
- 皮膚刺激性試験:刺激性なし(スコア0/5)
- 眼刺激性試験:刺激性なし(スコア0/5)
- アレルギー誘発性試験:陰性(0/100被験者)
- 吸入毒性試験:有害性なし
経済的効率性の分析
初期コストだけでなく、長期的な使用コストを考慮すると、JPzobeクリーナーは従来品と比較して優れた経済性を示します。濃縮配合により1本で約200回の使用が可能であり、1回あたりのコストは従来品の約60%に抑えられています。
| コスト項目 | 従来品(塩素系) | 従来品(酸性) | JPzobeクリーナー |
|---|---|---|---|
| 製品価格(500ml) | ¥680 | ¥580 | ¥880 |
| 使用回数 | 約100回 | 約120回 | 約200回 |
| 1回あたりコスト | ¥6.8 | ¥4.8 | ¥4.4 |
| 年間コスト(週2回使用) | ¥707 | ¥499 | ¥458 |
| 5年間総コスト | ¥3,535 | ¥2,495 | ¥2,290 |
実用的な使用方法と最大効果の実現

科学的に実証された効果を実際の使用環境で最大限に引き出すためには、適切な使用方法を理解することが重要です。以下に、微生物学的観点から最適化された使用手順を示します。
最適な使用手順
- 予備洗浄 - まず、便器表面の大きな汚れを水で流します。これにより、塩溶液が直接細菌に作用できる環境を整えます。
- 均一な塗布 - JPzobeクリーナーを便器全体に均一にスプレーします。特に水際や裏側など、細菌が繁殖しやすい箇所を重点的に処理します。
- 接触時間の確保 - 最低5分間、製品を表面に接触させたままにします。この時間が浸透圧による細菌破壊に必要です。
- ブラッシング - トイレブラシで軽く擦ることで、バイオフィルムの物理的除去と塩溶液の浸透を促進します。
- すすぎ - 十分な水で洗い流します。塩は完全に水溶性なので、残留物の心配はありません。
使用頻度の推奨
一般家庭での使用において、週2回の定期的な使用が推奨されます。この頻度により、細菌の増殖サイクルを効果的に抑制し、常に衛生的な状態を維持できます。公共施設や高頻度使用環境では、毎日の使用が推奨されます。
プロフェッショナルのヒント
清掃業界のプロフェッショナルからの推奨事項:夜間の使用が特に効果的です。就寝前に塗布し、一晩放置することで、塩溶液が長時間作用し、頑固なバイオフィルムも完全に除去できます。朝の洗浄で、驚くほど清潔な便器を実感できます。
結論:科学に裏付けられた次世代トイレ衛生管理
本記事で紹介した包括的な研究結果と専門家の見解は、JPzobeクリーナーが単なる清掃製品ではなく、科学的根拠に基づいた革新的な衛生管理システムであることを明確に示しています。塩の抗菌特性という自然の力を最新の科学技術で最適化することで、従来の化学系クリーナーを超える性能を実現しています。

主要な科学的知見のまとめ
- 塩の浸透圧メカニズムにより、99.99%の除菌率を5分以内に達成
- 薬剤耐性菌(MRSA)に対しても従来品を25%上回る効果を実証
- 物理的作用メカニズムにより、細菌の耐性獲得を完全に回避
- 環境負荷ゼロ、使用者への健康リスクゼロを実現
- 長期的なコスト効率において従来品を上回る経済性
世界的な薬剤耐性菌問題が深刻化する中、JPzobeクリーナーのような塩ベースの消毒技術は、公衆衛生の未来において重要な役割を果たすことが期待されています。科学的根拠に基づいた製品選択が、個人の健康だけでなく、地球環境の保護にも貢献します。
今後の研究展開
現在、複数の研究機関において、JPzobeクリーナーの技術を他の衛生管理分野に応用する研究が進行中です。キッチン衛生、医療施設の消毒、食品加工施設の衛生管理など、幅広い分野での応用可能性が検討されています。塩ベース消毒技術の未来は、さらなる科学的発展とともに広がり続けています。
JPzobeクリーナーは、古代からの知恵と最新科学の融合により、トイレ衛生管理に革命をもたらしました。この製品を選択することは、科学的に実証された効果、環境への配慮、そして家族の健康を守る賢明な選択です。